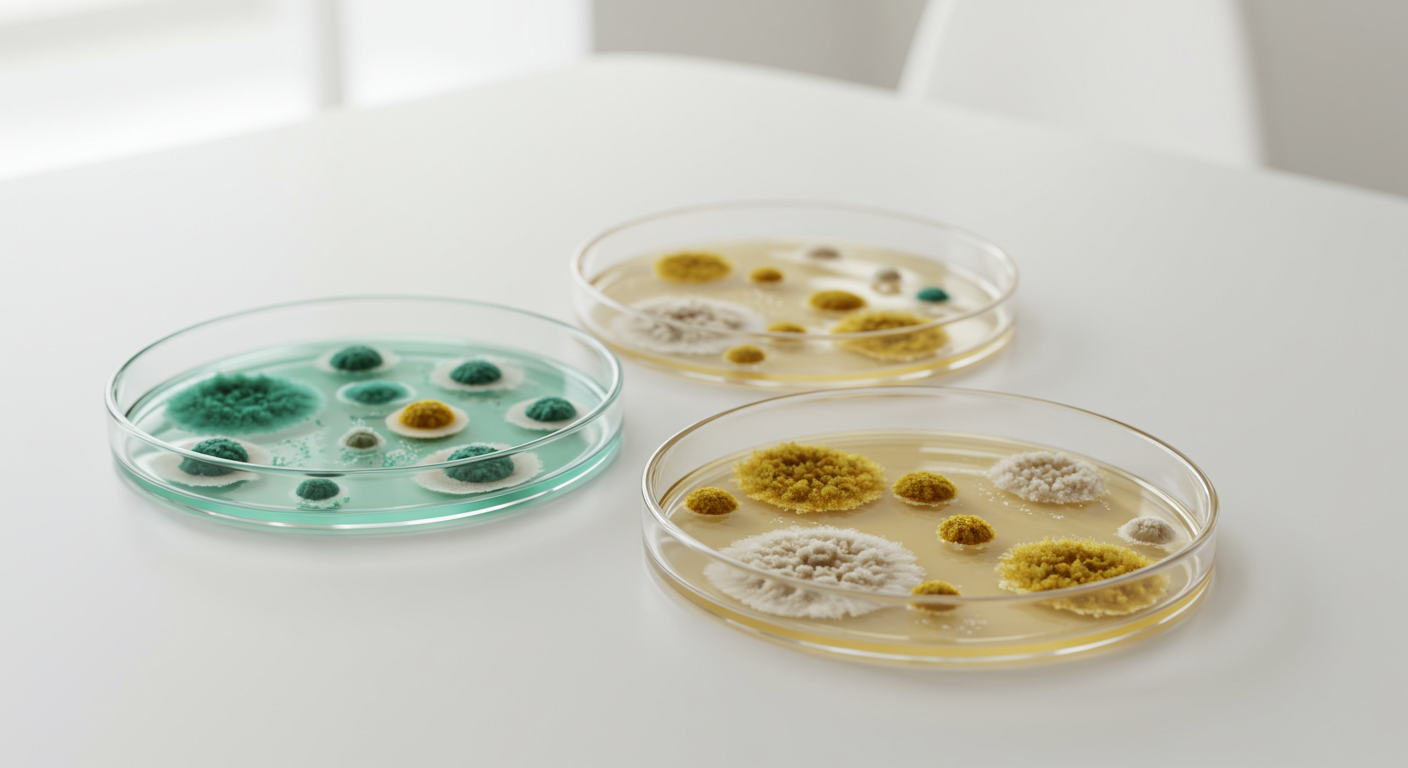
Types de moisissures : aperçu et différences

La moisissure dans une maison est bien plus qu'une simple tache disgracieuse sur le papier peint ou le mastic silicone. Il s'agit d'un phénomène biologique complexe qui, s'il est ignoré, peut avoir de graves conséquences sur la santé et révèle souvent des défauts structurels importants ou une ventilation insuffisante. Quiconque pense que « toutes les moisissures sont identiques » se trompe lourdement. Le monde des champignons est vaste : on connaît plus de 100 000 espèces, dont beaucoup trouvent des conditions de vie idéales dans nos habitations. Pour lutter efficacement contre les infestations de moisissures et évaluer correctement les risques pour la santé, il est essentiel de savoir distinguer les différents types de moisissures. Cet article vous propose un aperçu complet et scientifiquement rigoureux des types de moisissures les plus courants, de leurs caractéristiques spécifiques, des dangers potentiels et des mesures d'assainissement nécessaires.
Les informations les plus importantes en un coup d'œil
- Diversité : Tous les revêtements noirs ne sont pas de la fameuse « moisissure noire ». Un diagnostic définitif nécessite souvent des analyses en laboratoire.
- L'humidité comme principale cause : tous les types de moisissures ont besoin d'humidité. Le risque augmente de façon exponentielle à une humidité relative de 60 à 70 %.
- Risques pour la santé : Le danger varie considérablement selon le type de champignon, allant des réactions allergiques et de l’asthme aux effets toxiques des mycotoxines.
- Action : Les petites surfaces (< 0,5 m²) peuvent souvent être nettoyées par vous-même ; les infestations plus importantes doivent être laissées aux professionnels.
- Prévention : Une ventilation et un chauffage adéquats, ainsi que l'élimination des ponts thermiques, constituent la protection la plus efficace.
Notions de base : Qu’est-ce que la moisissure exactement ?
Les moisissures ne sont ni des plantes ni des animaux. Elles constituent un règne à part. À l'intérieur, elles se présentent généralement sous forme de champignons filamenteux formant un réseau invisible à l'œil nu, appelé mycélium. Ce que nous percevons comme une « tache de moisissure » n'est autre que la structure porteuse de spores qui assure leur reproduction. Ces spores sont omniprésentes dans l'air. Selon l'Agence fédérale allemande de l'environnement, la moisissure ne devient problématique que lorsque les spores entrent en contact avec des surfaces humides à l'intérieur et y germent [1] .
Les moisissures ont besoin de trois facteurs principaux pour se développer : l’humidité, des nutriments (comme la cellulose présente dans le papier peint, le bois ou la poussière) et une température adéquate. Comme les températures intérieures sont idéales pour la plupart des champignons, l’humidité est le facteur limitant sur lequel nous pouvons agir.
Classification par couleur : La première impression visuelle
En pratique, les moisissures sont souvent initialement classées selon leur couleur. Bien que cette méthode soit scientifiquement inexacte, car une même espèce peut présenter différentes couleurs et différentes espèces peuvent se ressembler, elle constitue un premier point de repère pour les personnes concernées.
1. Moisissure Noire (La Redoutée)
Le terme « moisissure noire » est celui qui suscite le plus d'inquiétude chez les locataires et les propriétaires. Il désigne souvent le champignon Aspergillus niger (moisissure de l'arrosoir), extrêmement résistant. On le trouve fréquemment dans les pièces humides comme les salles de bains, sur les joints de carrelage ou sur les murs exposés à la condensation.
Plus problématique encore, bien que moins fréquent, est Stachybotrys chartarum . Ce champignon nécessite une humidité très élevée (souvent après un dégât des eaux) et produit de puissantes mycotoxines (satratoxines) qui peuvent être inhalées. L’Office régional de la santé du Bade-Wurtemberg souligne que, contrairement à d’autres espèces , Stachybotrys ne libère pas facilement ses spores dans l’air ; celles-ci restent souvent emprisonnées dans son enrobage visqueux jusqu’à ce qu’elles sèchent et soient remises en suspension [3] .
2. Moisissure verte
La moisissure verte est probablement la plus courante sur les aliments, mais elle est également fréquente sur les murs. Il s'agit généralement d'espèces du genre Aspergillus (par exemple, Aspergillus fumigatus ) ou Penicillium .
Aspergillus fumigatus est particulièrement préoccupant pour les personnes immunodéprimées, car il peut provoquer des infections pulmonaires (aspergillose) [2] . La moisissure verte forme souvent un revêtement duveteux. Bien qu'elle soit souvent considérée comme moins agressive que la « vraie » moisissure noire (Stachybotrys), elle constitue un allergène potentiellement puissant en raison de sa forte dissémination de spores.
3. Moisissure blanche
La moisissure blanche est insidieuse car elle passe souvent inaperçue pendant longtemps sur les murs clairs ou les enduits. Lorsqu'elle est enfin découverte, l'infestation est souvent déjà bien avancée. Par la suite, elle peut prendre une teinte foncée.
Risque de confusion : La moisissure blanche est souvent confondue avec l'efflorescence saline, qui se produit dans les maçonneries humides lorsque des sels minéraux cristallisent.
- Si la matière se dissout ou a une texture sableuse/cristalline, il s'agit généralement de sels inoffensifs.
- Si la surface paraît grasse, visqueuse ou s'il reste de fins filaments, il s'agit très probablement de moisissure .
4. Moisissures jaunes et rouges
La moisissure jaune (souvent due à Aspergillus flavus ) est moins fréquente dans les habitations de ce pays, mais elle est dangereuse. Elle produit des aflatoxines, substances cancérigènes qui peuvent endommager le foie et les reins. Elle se développe de préférence sur des matières organiques comme les tissus en coton ou les surfaces à base d'amidon.
La moisissure rouge (par exemple, Neurospora ou Fusarium ) se développe souvent sur des substrats à base de céréales ou dans des environnements très humides comme les salles de bains sur des substrats cellulosiques (moisissure du boulanger).
Classification scientifique : Les genres les plus importants
Pour évaluer précisément le risque, la couleur seule ne suffit pas. Les laboratoires analysent le genre et l'espèce selon la norme DIN EN ISO 16000-17 [5] . Voici un aperçu des genres les plus courants dans les espaces de vie :
Aspergillus (moisissure de l'arrosoir)
Ce genre comprend certains des champignons d'intérieur les plus courants. Ils tolèrent très bien les variations de température.
- On les trouve sur : les murs, les meubles, le terreau, les aliments.
- Santé : Potentiel allergène élevé ; A. fumigatus et A. flavus peuvent provoquer des infections et des intoxications.
Penicillium (moisissure en brosse)
Avec plus de 200 espèces, ils sont très répandus. Ils poussent souvent plus vite que d'autres champignons et nécessitent un peu moins d'humidité que, par exemple, le Stachybotrys.
- Présence : Papier peint, matelas, aliments (moisissures d'agrumes).
- Santé : Principalement des réactions allergiques (nez qui coule, toux, irritations cutanées).
Alternaria
Ce champignon se rencontre aussi bien à l'extérieur qu'à l'intérieur. Il est considéré comme l'un des allergènes les plus importants au monde.
- Apparition : Cadres de fenêtres (condensation), textiles, murs humides.
- Santé : Allergène puissant, déclenche souvent des crises d'asthme.
Cladosporium
Ce phénomène se produit souvent en été, car les insectes sont transportés par le vent depuis l'extérieur et se déposent dans les endroits humides (par exemple, les joints de réfrigérateur, les encadrements de fenêtres). Ils forment généralement des colonies noires à vert olive.
Risques sanitaires en détail
Les effets des moisissures sur la santé sont souvent sous-estimés ou mal attribués. L’Organisation mondiale de la santé (OMS) indique que les personnes vivant dans des logements humides et infestés de moisissures présentent un risque accru de 75 % de maladies respiratoires et d’asthme [4] .
On distingue trois modes d'action :
- Réaction allergique : C’est la réaction la plus fréquente. Les spores agissent comme des allergènes inhalés. Les symptômes incluent des brûlures oculaires, un écoulement nasal, une toux sèche et de la fatigue.
- Effets toxiques : Les mycotoxines (toxines fongiques) sont des produits du métabolisme non volatils qui adhèrent aux spores ou aux particules de poussière. Ingérées, elles peuvent avoir des effets neurotoxiques ou immunosuppresseurs.
- Effet infectieux : les mycoses. Celles-ci n’affectent généralement que les personnes immunodéprimées (par exemple après une transplantation ou pendant une chimiothérapie), chez lesquelles le champignon se développe dans les tissus de l’organisme [2] .
Détection et traitement : que faire en cas d'infestation ?
La première étape consiste toujours à identifier la cause. Sans éliminer la source d'humidité (par exemple, une canalisation percée, une fissure dans la façade ou une ventilation insuffisante), les moisissures réapparaîtront inévitablement. L'Agence fédérale allemande de l'environnement recommande la catégorisation suivante pour l'assainissement [1] :
Catégorie 1 : Infestation à petite échelle (< 0,5 m²)
Les moisissures superficielles (par exemple, dans les joints en silicone ou sur de petites taches sur le papier peint) peuvent souvent être éliminées par l'utilisateur.
- Portez des gants, un masque (FFP2/FFP3) et des lunettes de sécurité.
- Utilisez de l'alcool éthylique à 70-80 % (alcool dénaturé) ou du peroxyde d'hydrogène.
- Attention au vinaigre : s’il neutralise de nombreux champignons, sur les murs calcaires (plâtre), il forme des sels organiques avec la chaux, créant ainsi un milieu idéal pour le développement des moisissures. Par conséquent, le vinaigre est souvent contre-productif sur les murs !
Catégorie 2 : Infestation à grande échelle (> 0,5 m²)
Il est nécessaire de faire appel à une entreprise spécialisée. Les matériaux contaminés (plaques de plâtre, enduit, isolation) doivent souvent être entièrement retirés. Des barrières anti-poussière et des systèmes de dépression sont indispensables pour empêcher la propagation des spores dans l'appartement.
Prévention : La règle des 60 %
La meilleure protection contre tous les types de moisissures est le contrôle de l'humidité. Les spores de moisissures cessent généralement de se développer lorsque l'humidité relative est constamment inférieure à 60 % (à la surface des murs, et pas seulement au centre de la pièce !). Utilisez un hygromètre et aérez en ouvrant grand les fenêtres pendant 5 à 10 minutes afin de renouveler l'air intérieur humide et de le remplacer par de l'air extérieur sec [6] .
Foire aux questions (FAQ)
Puis-je déterminer si une moisissure est toxique simplement en la regardant ?
Non. La couleur peut donner des indications, mais elle ne garantit pas l'innocuité. Les moisissures vertes peuvent aussi produire des toxines, et toutes les moisissures noires ne sont pas des Stachybotrys, une espèce hautement toxique. Seule une analyse en laboratoire d'un échantillon ou un test de contact peut apporter une certitude.
Les peintures anti-moisissures offrent-elles une solution durable ?
Les peintures anti-moisissures contiennent des fongicides qui inhibent la prolifération des moisissures. Toutefois, cet effet s'estompe avec le temps (souvent après 1 à 2 ans). Si la source d'humidité n'est pas traitée, des moisissures se développeront sur la peinture, voire la pénétreront.
L'odeur de moisissure est-elle dangereuse en l'absence de moisissure visible ?
Oui. Une odeur de moisi et de terre (COVM – composés organiques volatils microbiens) indique une prolifération active de moisissures, souvent dissimulées derrière les placards, le papier peint ou sous le plancher. Même sans tache visible, les spores peuvent polluer l'air.
Dois-je déménager immédiatement en cas d'infestation de moisissures ?
Pas nécessairement. Cela dépend de l'ampleur de l'infestation et de l'état de santé des occupants (groupes à risque comme les nourrissons ou les asthmatiques). Toutefois, en cas d'infestation très importante ou de détection de Stachybotrys , un appartement peut être inhabitable jusqu'à la fin des travaux de décontamination.
Comment puis-je bien aérer si je ne suis pas chez moi toute la journée ?
Aérez bien la pièce le matin après vous être levé (pour évacuer l'humidité de la chambre) et le soir immédiatement après votre retour à la maison et avant de vous coucher. Cela suffit généralement s'il n'y a pas de sources d'humidité (linge qui sèche, cuisine) pendant la journée.
Conclusion
Distinguer les différents types de moisissures est complexe, mais essentiel à l'évaluation des risques. Si la quasi-totalité des spores de moisissures présentes dans les espaces intérieurs doivent être éliminées pour des raisons d'hygiène, l'urgence et le type d'intervention varient selon l'espèce et l'étendue de l'infestation. Il ne faut jamais ignorer les premiers signes, tels que de petites taches de moisissure ou une odeur de renfermé. L'humidité est primordiale : maîtriser le climat intérieur prive la plupart des types de moisissures – qu'elles soient noires, vertes ou blanches – de leur milieu de développement. Agissez préventivement et, en cas de doute, consultez toujours un spécialiste en biologie du bâtiment ou un expert afin de protéger votre santé et la structure du bâtiment à long terme.
Sources et références
- Agence fédérale allemande pour l'environnement (UBA), « Guide pour la prévention, la détection et le traitement des infestations de moisissures dans les bâtiments », 2017.
- Institut Robert Koch (RKI), « Risques pour la santé liés aux moisissures dans les espaces intérieurs », Bulletin fédéral de santé, 2007.
- Office régional de la santé du Bade-Wurtemberg, « Moisissures dans les espaces intérieurs - détection, évaluation, gestion de la qualité », 2014.
- Organisation mondiale de la santé (OMS), « Directives de l’OMS pour la qualité de l’air intérieur : humidité et moisissures », 2009.
- DIN EN ISO 16000-17:2008, « Pollution de l'air intérieur - Partie 17 : Détection et dénombrement des moisissures ».
- Centre de conseils aux consommateurs, « Humidité et développement de moisissures dans les espaces de vie », en date de 2023.

>
>

Kommentare (0)
Schreibe einen Kommentar
Kommentare werden vor der Veröffentlichung geprüft.